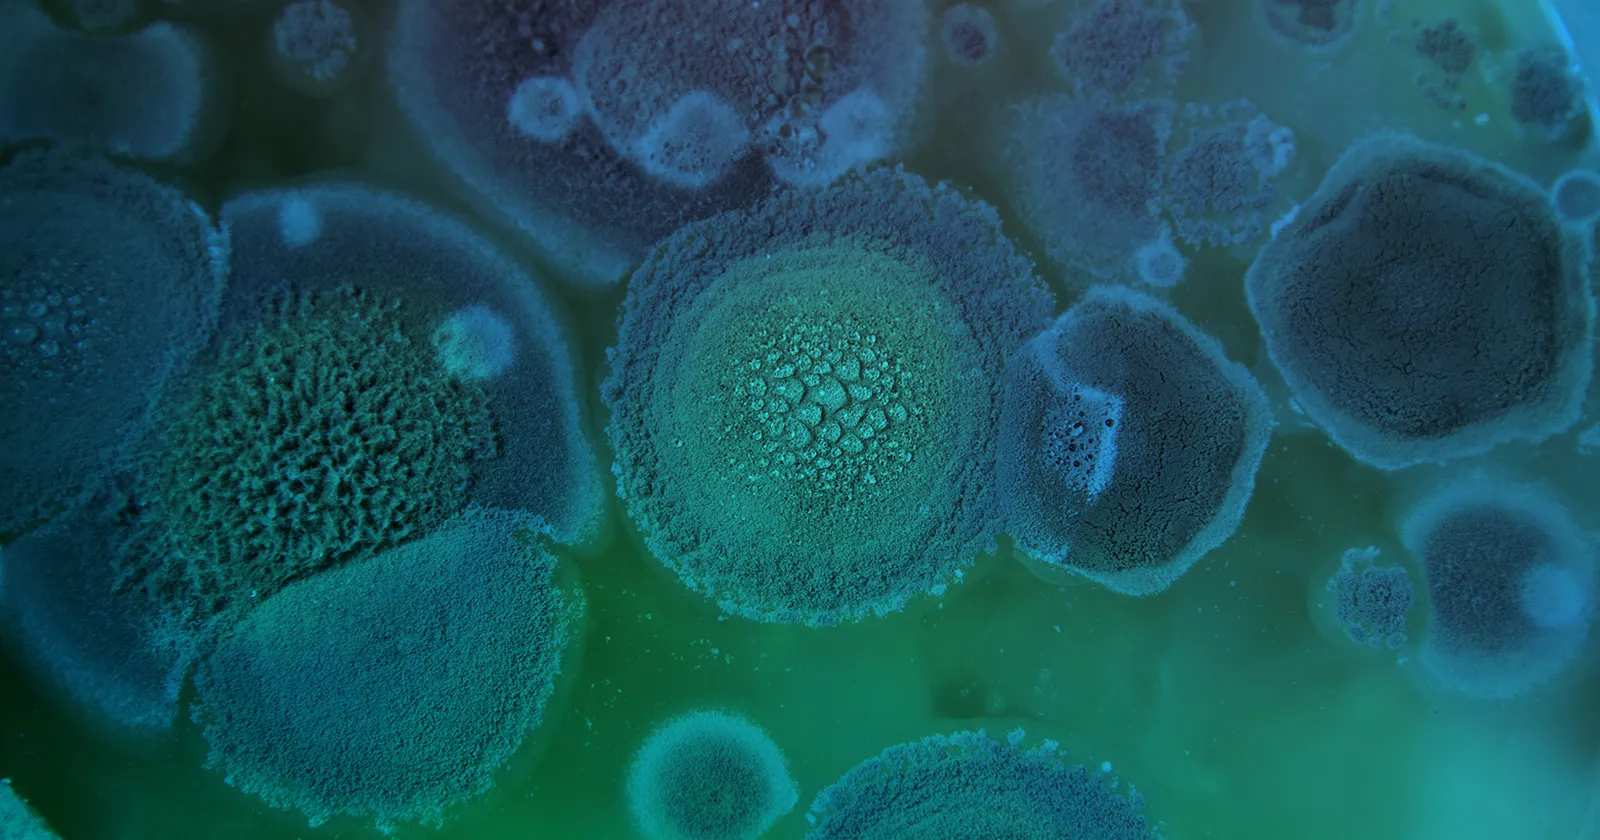
Health Sciences

Bring Us Your Toughest Challenges

What's Your Product's Outlook?
AI is reshaping every phase of your total product lifecycle, surfacing new opportunities — and questions. How will I manage my messy data? Is my patient information secure? How will software updates change my product compliance over time? How will hallucinations impact efficacy and performance? How can I protect my IP?
Things can happen at any stage. Exponent brings deep AI and multidisciplinary domain expertise to solve challenges and investigate failures, offering end-to-end support for AI applications in medical devices, pharma, biotech, digital health, and more.
Failure Analysis Is in Our DNA
Exponent delivers independent, objective analysis, so you can understand how your AI is actually working, where risks can emerge, and how to mitigate them — from specific fixes to long-term design and validation improvements.

Healthy Models. Healthy Outputs.
For decades, we've been supporting leading global pharma, medical device, biotech, and visionary startups as they evaluate product safety and performance and define targeted regulatory strategies. When obstacles or challenges arise, we rapidly mobilize our multidisciplinary teams to understand why and what to do about it.
Healthy Models. Healthy Outputs.
For decades, we've been supporting leading global pharma, medical device, biotech, and visionary startups as they evaluate product safety and performance and define targeted regulatory strategies. When obstacles or challenges arise, we rapidly mobilize our multidisciplinary teams to understand why and what to do about it.
how we help clients
Gain confidence when it matters most
Exponent offers clients multidisciplinary failure analysis rigor and regulatory expertise across data sciences, health sciences, biomedical engineering, human factors, and biomechanics. We map failure modes, diagnose root causes, identify edge cases, and evaluate where models are vulnerable to security, hardware, or integration breakdowns — extending the same methods long used in high-risk physical systems to AI embedded in devices, diagnostics, and digital health therapies.
When AI performance, device behavior, or clinical results are challenged, we deliver defensible technical insights for regulatory reviews, product investigations, IP disputes, and high-stakes claims.
Good data is good medicine
Exponent helps you overcome data collection challenges and gain speed to market by sourcing, integrating, and strengthening your modeling inputs. We help you extract more value from what you already have, close critical information gaps, and validate performance using scientific and engineering first principles.
Sharpen postmarket surveillance
Whether you're updating labeling, refining next‑generation designs, or tracking early signs of adverse events or hardware failure, we help you optimize your surveillance with AI-driven insights. Exponent helps you use AI to synthesize real-world data from electronic health records (EHRs), registries, sensors, complaints, and usage logs, so you can quickly spot issues. We detect safety signals, identify emerging patterns, and investigate issues to reveal root causes and guide corrective actions. When regulators or courts ask tough questions, we provide defensible narratives rooted in objective, independent technical understanding.
Our Capabilities Are Unparalleled
When the stakes are high, Exponent brings deep scientific, engineering, and data sciences expertise to help you solve complex product, safety, and regulatory challenges with clarity and speed.

Decentralized Clinical Trials Consulting
Fit-for-purpose digital technology evaluations, remote monitoring, and bespoke end-to-end deployment support.

Medical Technology Assessment Program
Rapid, expert assessments of medical devices and technologies, surgical implants, and wearable medical technologies.

Pharmaceuticals: Chemistry, Manufacturing & Controls
Evaluate next-generation pharmaceuticals with support for research, development, and formulation.

Multidisciplinary Expertise for Pharmaceutical Testing & Modeling
Evaluate pharmaceuticals with pharmacodynamic modeling, clinical epidemiology, and pharmacoepidemiology studies.

Biomechanical Testing & Modeling
Uncover the root cause of injuries with robust and advanced biomechanical analysis.
![User Research & Testing [HF]](/sites/default/files/styles/cards_home_card/public/media/images/GettyImages-1338374024.jpg.webp?itok=bBXBoCIg)
Medical Device Usability Testing
Extensive human factors evaluations for medical device manufacturers in developing and navigating regulatory roadmaps.

Digital Health Data, Device & Research Solutions
When your digital health product depends on high‑quality, hard‑to‑obtain data, Exponent builds fit‑for‑purpose solutions that solve pain points — from messy datasets and device performance questions to regulatory uncertainty.

Use AI with Confidence
AI offers immense opportunity — but also introduces risk, particularly in high-consequence sectors where safety, trust, and security are non-negotiable. Achieving confidence with AI requires insights rooted in rigorous science and engineering.

Redefine What's Possible
When device performance, safety risks, and compliance questions threaten your timelines, Exponent helps you get answers fast. From custom testing to failure analysis, corrosion, MRI compatibility, and biocompatibility challenges, our multidisciplinary experts deliver the insights you need to move forward with confidence.

![Real World Evidence [BES]](/sites/default/files/styles/cards_hover/public/media/images/GettyImages-1136089173.jpg.webp?itok=E3iDYr37)



